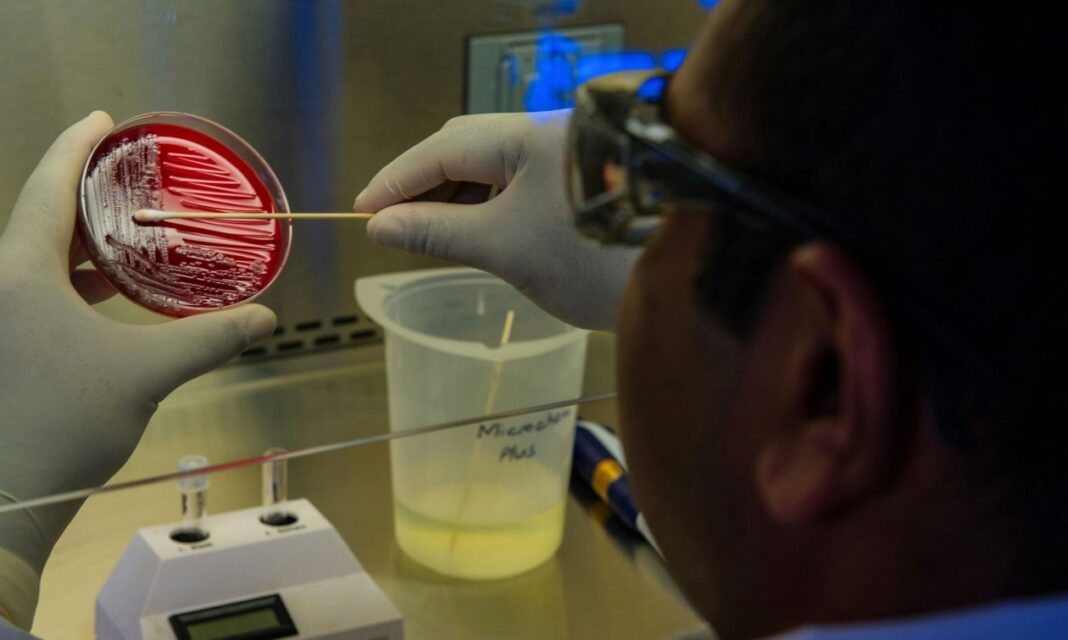

Σιωπηλή πανδημία η μικροβιακή αντοχή – Τι συμβαίνει με τα βακτήρια
Ο πόλεμος στην Ουκρανία αναδεικνύει τα μεταλλαγμένα υπερβακτήρια που μπορούν να αντισταθούν στα αντιβιοτικά.
Η περίπτωση ενός στρατιώτη του οποίου το πόδι ακρωτηριάστηκε σε νοσοκομείο της Βρετανίας, επειδή τα αντιβιοτικά δεν μπορούσαν να αντιμετωπίσουν τη μόλυνση του είναι σημάδι μιας αυξανόμενης κρίσης, λένε οι γιατροί.
Αναλυτικότερα, γιατροί βρήκαν βακτήρια ανθεκτικά στα αντιβιοτικά σε στρατιωτικό προσωπικό που τραυματίστηκε στην Ουκρανία, γράφουν οι Times. Τέτοιους μικροοργανισμούς εντόπισαν γιατροί από το νοσοκομείο St. George στο Λονδίνο στο τραυματισμένο πόδι ενός Ουκρανού στρατιώτη. Ο άνδρας μεταφέρθηκε στο Ηνωμένο Βασίλειο για θεραπεία. Τα τραύματά του αντιμετωπίστηκαν με διάφορα φάρμακα, μεταξύ των οποίων και αντιβιοτικά, αλλά το άκρο του δεν σώθηκε και το πόδι του ακρωτηριάστηκε.
Παρόμοια κρούσματα σημειώθηκαν σε νοσοκομεία της Γερμανίας, της Ολλανδίας και της Νορβηγίας, όπου νοσηλεύεται ουκρανικό στρατιωτικό προσωπικό.
Το περιστατικό στην Βρετανία
Όταν ο στρατιώτης έφτασε από τα πεδία των μαχών της Ουκρανίας, η βρετανική ιατρική ομάδα ανησυχούσε – αρχικά – περισσότερο για τα εκτεταμένα τραύματα από θραύσματα.
Όταν όμως καθάρισαν τα τραύματα του 35χρονου, οι γιατροί του νοσοκομείου St George’s στο νότιο Λονδίνο συνειδητοποίησαν ότι είχαν να αντιμετωπίσουν ένα μεγαλύτερο πρόβλημα. Βαθιά μέσα στα τραύματα από τις εκρήξεις στο αριστερό του πόδι, μια βακτηριακή λοίμωξη είχε κάνει την εμφάνισή της.
Ένα αρχικό κοκτέιλ πέντε διαφορετικών αντιβιοτικών απέτυχε να σκοτώσει τα βακτήρια. Καθώς το τραύμα εξακολουθούσε να φθείρεται, άλλαξαν τακτική για να δοκιμάσουν άλλα τέσσερα φάρμακα, συμπεριλαμβανομένης της κολιστίνης, ενός αντιβιοτικού «κορυφαίου» με σοβαρές παρενέργειες, το οποίο προορίζεται για περιπτώσεις όπου τίποτα άλλο δεν αποδίδει. Αλλά και αυτά, επίσης, είχαν περιορισμένη επίδραση.
Δυστοπικό μέλλον
Εδώ και δεκαετίες οι γιατροί προειδοποιούν για ένα δυστοπικό μέλλον στο οποίο τα αντιβιοτικά θα καταστούν άχρηστα. Σε αυτόν τον θάλαμο του βρετανικού συστήματος υγείας τον Νοέμβριο του 2022, η ζοφερή προοπτική δεν ήταν πλέον μακρινή. Σε ένα από τα πιο εξειδικευμένα νοσοκομεία τραύματος της Βρετανίας, οι χειρουργοί αναγκάστηκαν να υποχωρήσουν σε μεσαιωνικές μεθόδους.
Για να σώσουν τη ζωή του στρατιώτη από τα μεταλλαγμένα υπερβακτήρια, αναγκάστηκαν να ακρωτηριάσουν το πόδι του από το γόνατο.
Ο Δρ Luke Moore, σύμβουλος λοιμωδών νοσημάτων στο νοσοκομείο Chelsea and Westminster, ο οποίος κλήθηκε να συνδράμει στην περίπτωση του στρατιώτη, περιέγραψε την μικροβιακή αντοχή – γνωστή ως AMR – ως «σιωπηλή πανδημία».
Εάν τα βακτήρια συνεχίσουν να εξελίσσονται ώστε να αποφεύγουν τα φάρμακα, θα θέσει σε κίνδυνο ακόμη και την υγειονομική περίθαλψη ρουτίνας. Η αφαίρεση των αμυγδαλών ενός παιδιού για παράδειγμα θα έθετε σε κίνδυνο τη ζωή του, λένε Times.